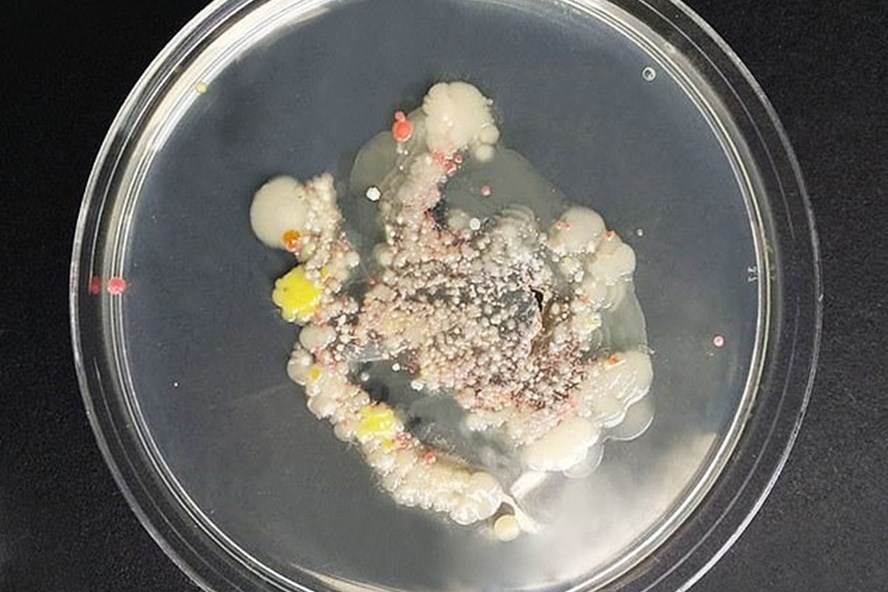
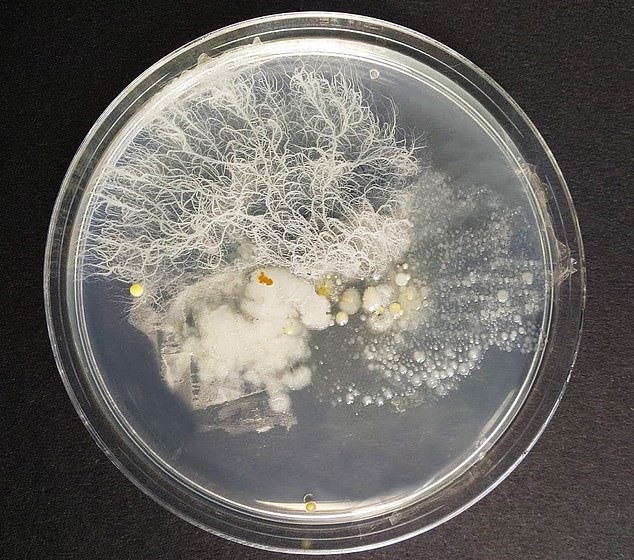
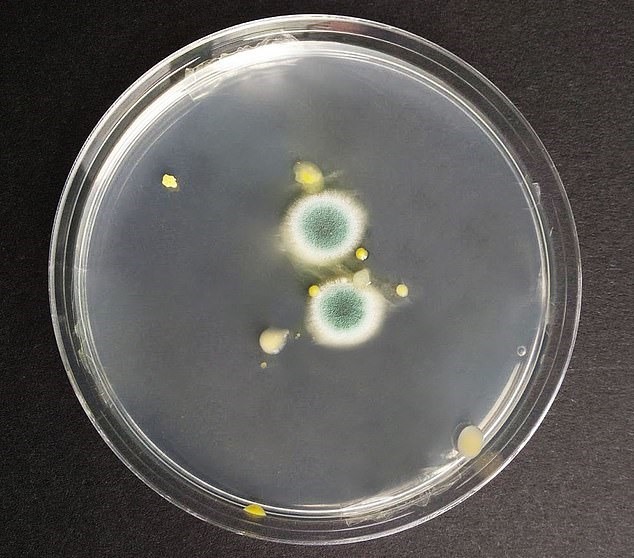

Danh mục sản phẩm
Sản phẩm nổi bật
Thủ phạm bất ngờ giấu mầm bệnh sinh sôi trong ôtô của bạn
Thủ phạm bất ngờ giấu mầm bệnh sinh sôi trong ôtô của bạn
Sau 5 ngày, mầm bệnh ngày càng mở rộng và các đốm đỏ - được cho là dấu vết của Serratia marcescens, có khả năng kháng thuốc kháng sinh, xuất hiện ở đồ chơi cho chó. Ảnh: Daily Mail.
Chính các vật dụng chứ không phải thực phẩm lại là nơi sản sinh hoàn hảo của mầm bệnh chỉ sau vài ngày để trong ôtô.
Một nghiên cứu được thực hiện bởi nhóm vi sinh vật tại Đại học London Metropolitan (Anh) đã phát hiện ra rằng, các vật dụng để trong ôtô là nơi sinh sản hoàn hảo của những mầm bệnh nguy hiểm chỉ sau vài ngày, Daily Mail đưa tin.
Dù tháng 7 vừa qua không quá nóng, nhưng nhiệt độ bên trong xe ôtô lên tới 33 độ C - cao hơn cả nhiệt độ trung bình mùa hè ở Hy Lạp.
Những mầm bệnh bắt đầu sinh sôi trên 16 vật dụng trong vòng vài ngày, trong đó đặc biệt phải kể đến kính râm, túi nilon, ti giả cho trẻ em và hóa đơn.
Đáng ngạc nhiên, thử nghiệm cho thấy những đồ không phải thực phẩm thường được để trong xe nhiều ngày tạo ra nhiều vi khuẩn hơn bao bì thực phẩm và đồ uống.
Đặc biệt đối với kính râm, khi để trong xe vài ngày với nhiệt độ ấm áp, kính râm bị nhiễm vi khuẩn Staphylococcus epidermidis - có thể gây nhiễm trùng.
Khi để trong xe ôtô hai ngày, cặp kính râm được kiểm tra đã bắt đầu tích tụ mầm bệnh và bị nhiễm Staphylococcus epidermidis rất cao. Ảnh: Daily Mail.
Đối với túi nilon, trên bề mặt hình thành loại nấm mốc xanh độc hại, cực kỳ nguy hiểm cho những người có vấn đề về hô hấp. Việc ăn phải nấm mốc còn gây hại đặc biệt cho những người bị hen suyễn hoặc dị ứng.
Mầm bệnh - loại nấm mốc xanh độc hại đã bắt đầu tích tụ trên túi nilon sau 2 ngày để trong ô tô. Ảnh: Daily Mail.
Thường được dùng để dỗ trẻ em, ti giả được nhiều bậc phụ huynh coi là vật hỗ trợ đắc lực. Tuy nhiên, việc để ti giả lâu dài trong xe ôtô khiến đồ vật này có thể xuất hiện 1 loại nấm men - nguyên nhân phổ biến khiến trẻ bị nấm miệng.
.jpg)
Mầm bênh - nấm men sinh sôi trên ti giả của trẻ em khi để trong ôtô. Ảnh: Daily Mail.
Dù có thể điều trị bằng thuốc, các nhà khoa học khuyến cáo chỉ nên cho trẻ ngậm ti giả khi trẻ ở trong nhà. Ngoài ra, cần vứt bỏ khi đã để ti giả trong ôtô mà không bao giờ cho trẻ sử dụng tiếp.

Mầm bệnh - nấm mốc phát triển lan rộng dần trên hóa đơn sau 5 ngày để trong xe ô tô. Ảnh: Daily Mail.
Hóa đơn có lẽ là một trong những thủ phạm khá bất ngờ đối với nhiều người. Vài ngày bỏ trong ôtô, những tờ giấy tưởng chừng vô hại này phát triển nấm mốc có thể tạo ra các chất độc hại gây kích ứng, dị ứng và hen suyễn. Vì vậy, nên bỏ chúng đi nếu bạn không cần tới nữa.
Ngoài những đồ vật trên, đồ chơi cho thú cưng, quần áo hay giày tập thể dục, tiền xu, muỗng ăn kem, cốc giấy đựng cafe, chai nhựa đựng nước, giấy gói bánh cũng là "thủ phạm" sinh sôi mầm bệnh nguy hiểm trên xe ôtô.
LÊ THANH HÀ
Nguồn: https://laodong.vn/xe/thu-pham-bat-ngo-giau-mam-benh-sinh-soi-trong-oto-cua-ban-832585.ldo?fbclid=IwAR2s5K19L6AW8Le58U66Q0mmGwGlN0n3J2UxDdmJ_oJNiS7hJdbMrnA29r0
KHỬ MÙI XE HƠI
Hotline & Zalo: 0909.582.386
Địa chỉ: số 19 ngách 178/5 Tây Sơn, Đống Đa, Hà Nội
Website: http://khumuixehoi.com
Email: vinalike.vn@gmail.com
- NANOCAR -Viên nén nano khử mùi diệt khuẩn dành cho xe hơi
- Cơ chế diệt khuẩn của Nano Bạc
- NANOCAR- Khử mùi xe hơi
- Một số loại tinh dầu có thể để trong phòng ngủ
- Dùng tinh dầu trên ô tô giúp tinh thần sảng khoái nhưng cần lưu ý điều này
- Tinh dầu bạc hà
- Tinh dầu sả chanh
- Làm thế nào để ruồi, muỗi trong ô tô không còn là nỗi ám ảnh?
- Tuyệt đối không để 5 đồ vật này trong xe ô tô dưới trời nắng nếu không muốn nó nổ tung như bom
- 6 thứ có mùi thơm người Việt hay để trong nhà, trong xe nhưng cực kỳ độc hại, gây ung thư
- Bí quyết giữ lớp sơn xe ô tô bền đẹp, không bong tróc
- KHỬ MÙI Ô TÔ TOÀN QUỐC







.png)



